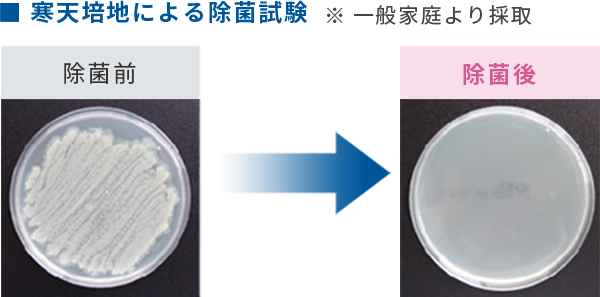
雑菌を除去し強力消臭

宮島はたくさんの方が訪れる有名な観光地です。コロナ禍でも安心して宮島に来ていただく為にも自分にできる最大限のコロナ対策をしようと思い、購入することにしました。
ウイルスだけでなく消臭効果や、花粉やダニの死がいなどのアレルギーの原因になっているものを分解してくれるという効果があるという事には非常に驚きました。
これ一つでいろんな対策をする事ができるので、いい買い物をしたなと満足しています。
また、広島にある会社だということもあり、何かあった時はすぐに対応してくださる対応力が素晴らしいと思っています。
営業から販売、購入後のアフターサービスまで同じ方が対応してくださり安心です。
P社の空間除菌脱臭機と比べ、ジアリフレ専用噴霧器は超音波式であるということもあり、音が非常に静かなことに大変驚きました。
また、注文した翌日には商品を届けてくださるという迅速な対応に大変驚きました。(P社の空間除菌脱臭機は納品までに半年もかかりました)
ジアリフレ専用噴霧器は、P社の空間除菌脱臭機の半額の値段で購入できるところも魅力的だなと思いました。
ジアリフレ専用噴霧器は次亜塩素酸自体を直接噴霧してくれるので、安心感があります。
子供たちとインコをウイルスから守りたいという思いから、ジアリフレと専用噴霧器を使用しています。
ジアリフレのおかげでインコは病気にかかることなく元気に毎日過ごしています。
室内で焼肉をすることが多々ありますが、噴霧器とジアリフレの併用で、焼肉後の家の臭いに対しあまり気にならなくなりました。
ウイルス対策や消臭効果だけではなく、加湿効果もあるので、乾燥がひどい冬の時期は大活躍しています。
購入して良かったと思います。



ジアリフレは、次亜塩素酸ナトリウム(上水道・プール等の除菌やカビ取り剤の成分)と希塩酸と水を特殊技術で混合・精製した弱酸性の水溶液です。
安全かつ除菌効果の高いpH領域(弱酸性 pH5.5~6.5程度)へ調整・混合することで、主成分である次亜塩素酸の除菌力を最大限に近い状態にした理想的な除菌消臭剤で、その除菌力は次亜塩素酸ナトリウムの約6~10倍です。
人間の体内で白血球が細菌とたたかうのに「次亜塩素酸」が作用していると言われています。次亜塩素酸は、様々な細菌やウイルス、悪臭を発生させる細菌類の働きを抑えます。ジアリフレは、次亜塩素酸ナトリウムと希塩酸と水を希釈混合した弱酸性の水溶液です。病院・食品工場・介護施設・ペットショップなどで幅広く使用されています。
お部屋の広さにもよりますが、20~30分程度で連続運転して頂ければ、かなり除菌が進んだ状態になると思われます。その後は、4~6分程度の間欠運転で除菌状態を維持することが可能です。あくまでも標準的なケースですので、お部屋の状況により変わります。
各種試験機関での検査(経口・目刺激性・皮膚刺激性)でも安全性が確認されています。
単回経口投与試験 … 異常は認められず
皮膚1次刺激性試験 … 刺激性なし
眼刺激性試験 … 無刺激物の範疇にある
試験機関 財団法人 日本食品分析センター
各種試験機関での検査結果より、赤ちゃんのいるお部屋でのご使用にも問題ありません。
哺乳瓶、おもちゃなどのベビー用品、つい口に入れてしまう物の除菌にも使用可能です(除菌後、哺乳瓶などを使用する前に水道水ですすぎが必要です)。
また、ペットのにおい、衛生管理にも効果的です。

| 広島市及び周辺エリア | 月 | 火 | 水 | 木 | 金 | |
|---|---|---|---|---|---|---|
| A | 江波南2 / 江波本町 / 観音新町 / 光南 / 舟入川口町 / 南観音 / 羽衣町 | |||||
| B | 庚午南1 / 草津 / 井口 / 五日市 / 観音台 / 廿日市 / 宮内 / 宮園 / 阿品 / 宮島口 / 大野屋 / 前空1 | |||||
| C | 庚午中1 / 古江 / 高須 / 己斐 / 美鈴が丘 / 八幡東 / 石内 / 大塚 / 伴東 / 伴中央 / 伴北 | |||||
| D | 舟入幸町 / 千田町 / 観音本町 / 十日市 / 八丁堀 / 中広 / 大芝 / 牛田 / 長束 / 祇園 / 中筋 / 大町 / 緑井 / 長楽寺 / あさひが丘 / 八木 | |||||
| E | 松原町 / 大洲 / 府中町 / 矢賀 / 温品 / 戸坂 / 馬木 / 口田 / 亀崎 / 上深川 / 深川 / 可部 / 亀山 | |||||
| F | 皆実町 / 出島 / 丹那 / 比治山 / 東雲 / 堀越 / 矢野 / 坂 / 海田町 / 中野 / 中野東 / 瀬野 / 瀬野西 | |||||
